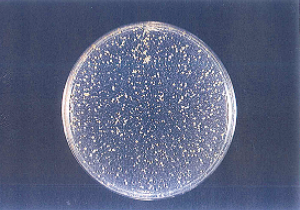
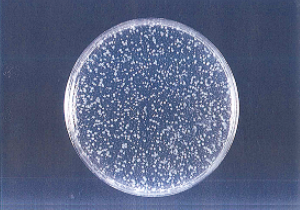

エアサクセスとは
What is Air Success?
コロナウイルス不活化の他、ユーザー様より以下のような相乗効果をお聞きしています。
✨✨✨屋内の不快な臭いがなくなった!✨✨✨
✨✨✨カビの繁殖がなくなった!✨✨✨
✨✨✨蚊やゴキブリが出なくなった!✨✨✨

エアサクセスとは
低濃度オゾンの効果と実験
藤田医科大学ウイルス学研究チームは、健康に影響がないとされる低い濃度(0.05ppm)のオゾンが、新型コロナウイルスの感染力を抑制する効果があることを世界で初めて実験で確認しました。
日本の作業基準で健康に影響がないとされる
「0.1ppm」感染力のあるウイルスの量→95.4%減少(10時間後)
室内環境基準値
「0.05ppm」感染力のあるウイルスの量→94.3%減少(20時間後)
※2020年9月より大学病院の待合室・病室等にオゾン発生機を設置、今後あらゆる場所に導入が見込まれます。(NHKニュース報道他)
低濃度オゾン風の発生概念図

除菌高価試験・ウイルス不活化試験(財団法人日本食品分析センター試験報告書・一般社団法人予防環境協会エビデンス)
インフルエンザウイルス不活化試験
|
|---|
MRSA(マース)

MRSA  MRSA ●MRSA(マース)は感染すると抗生物質が効きにくく、重症化すると死亡することもある。 |
黄色ブドウ球菌
黄色ブドウ球菌  黄色ブドウ球菌 ●ヒトや動物に様々な表皮感染症、敗血症などで死亡することもある |
サルモネラ菌

サルモネラ  サルモネラ ●ヒトをはじめ、牛や豚、自然界に生息。ハエやゴキブリから感染するので注意が必要。 |
大腸菌
大腸菌(O157:H7)  大腸菌(O157:H7) ●大腸菌で最も多い好気性共生細菌です。胃腸炎、尿路結石症等を引き起こす感染症。 |
アオカビ

アオカビ  アオカビ ●アオカビは不安全菌の一つであり、300種類以上あり、広く分布しており、注意が必要です。効果な和服のカビからの保護にも有効です。 |
低濃度オゾンはマスコミでも多く取り上げられ注目のウイルス対策
●エアーサクセスは日経記事にも取り上げられ、テレビ放映もされています。
●健康な人にも病原体として少なくとも39種類のウイルスが居着していることを東京大学のチームが突き止めました。(脳・肺・心臓・血液・肝臓・大腸など)※2020年6月21日日経新聞掲載)
●新型コロナウイルス除去等の効果は病院、介護施設でも確認されています。

←AirSuccess作動にて14日後の食パンのカビ






